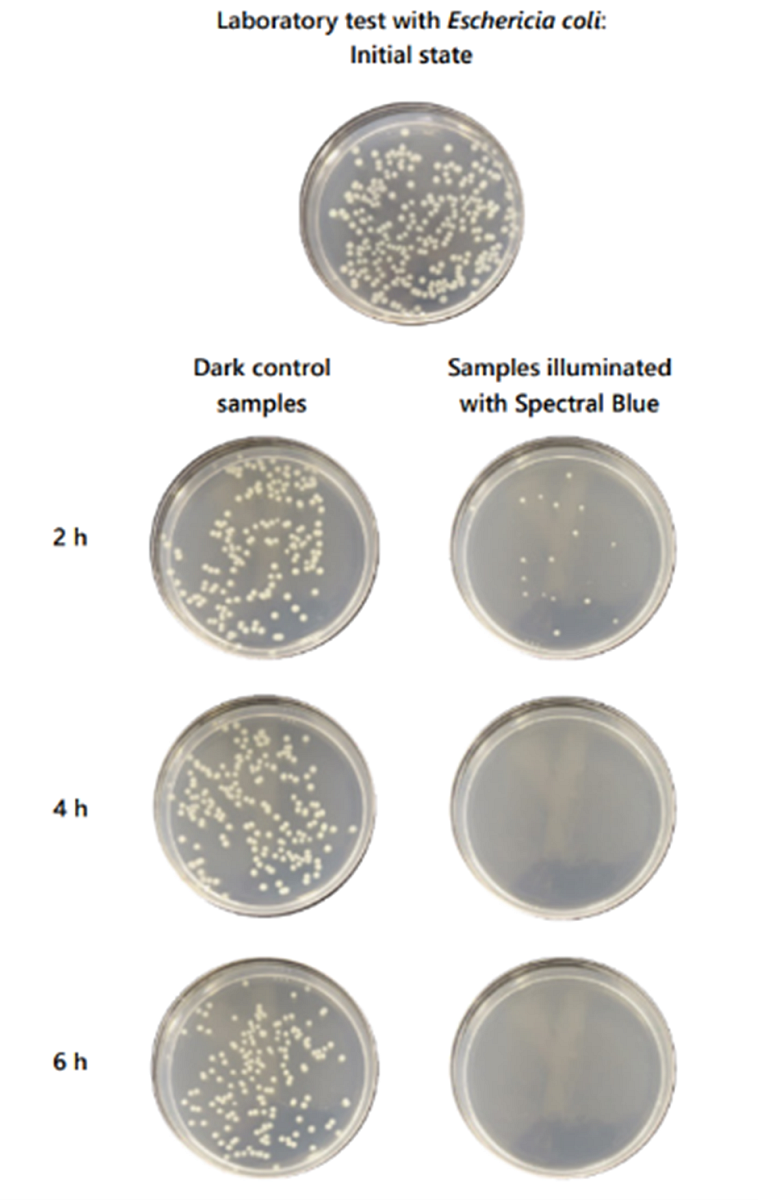

Spectral Blue – bezpečná dezinfekce prostor a povrchů pomocí modrého světla
Bezpečná dekontaminace vzduchu a povrchů
Spectral Blue jsou speciální vysokointenzitní LED panely, které využívají modré viditelné světlo o vícero vlnových délkách ke kontinuální dezinfekci povrchů a laboratorních nebo výrobních prostor. Je schopné eliminovat plísně, kvasinky i bakterie, včetně rezistentních bakterií rodu Staphylococcus a Enterobacter a inaktivovat virové částice. Díky tomu, že tato technologie nevyužívá UV záření ale viditelné světlo, je bezpečná pro lidi i materiály citlivé na UV a lze ji tedy použít pro kontinuální dekontaminaci i během pracovní doby. V následujících odstavcích si povíme, jak přesně tato technologie funguje.
Jak to přesně funguje?
Spectral Blue LED panely využívají technologii antimikrobiálního viditelného modrého světla (dále jen aBL) v oblasti 400-470 nm. Zatímco běžně používané ultrafialové záření poškozuje DNA všech organismů, antimikrobiální účinek modrého světla je zcela odlišný. Při ozáření mikrobů pomocí aBL dochází k fotoexitaci molekul, jako jsou porfyriny a flaviny, které jsou běžně přítomny v mikrobiálních buňkách, ale v lidských buňkách se nevyskytují nebo se vyskytují ve výrazně nižších koncentracích. To způsobí aktivaci reakční kaskády, která vede k tvorbě reaktivních forem kyslíkovu neboli ROS (z anglického reactive oxygen species) uvnitř mikrobiálních buněk. Ty pak způsobují poškození membrán, proteinů, nukleových kyselin, membrán a smrt buňky [1]. Díky faktu, že se tyto molekuly běžně nevyskytují v lidských buňkách, je možné pomocí aBL selektivně zabíjet pouze mikrobiální buňky bez jakéhokoliv nežádoucího účinku na člověka nebo buněčné kultury.
Nejčastěji používanou a testovanou vlnovou délkou aBL je 405 nm. Spectral Blue LED panely využívají tzv. Multi-Wavelength, High-Intensity (MWHI) technologii a kromě 405 nm používají také vysoce intenzivní LED delších vlnových délek, které umožňují fotoexcitaci většího počtu absorbujících sloučenin v jednom čase. To rozšiřuje použití na mnohem širší počet mikrobů a zajišťuje vyšší účinnost a rychlost dezinfekce. Dezinfekční účinek a redukce mikroorganismů v prostředí se se tak projeví již během několika hodin.

Obr. 1 Princip účinku antimikrobiálního modrého světla. Typická mikrobiální buňka obsahuje sloučeniny, které absorbují světlo, jako jsou flaviny a porfyriny. Ozáření aBL aktivuje reakční kaskády, která způsobí tvorbu reaktivních forem kyslíku (ROS) uvnitř buňky. ROS poškodí životně důležité buněčné struktury (lipidy, nuklové kyseliny, proteiny, membrány) a nejprve mikroby inaktivují a při delší expozici i zcela zabíjí.
Účinnost
Antimikrobiální účinky modrého světla jsou studovány už několik desetiletí a jeho účinky na různé druhy mikrobů jsou již dobře známé. Ve vědeckých databázích najdete přes 2000 článků z různých recenzovaných časopisů, kde byly testovány účinky na širokou paletu bakterií, plísní i kvasinek.
MWHI technologie Spectral Blue panelů je mnohem účinnější než klasický postup, kdy se používá jen jedna vlnová délka, a byl ověřen několika akreditovanými laboratořemi. Provedené testy ukázaly, že tyto panely jsou vysoce účinné proti běžným nemocničním patogenům, patogenům běžně přítomným v čistých prostorách a také patogenům v potravinářském průmyslu. Na Obr. 2 můžete vidět příklad účinku na bakterii E. coli.
Obr. 2 Inaktivace E. coli. Bakterie byly nasazeny na agarové plotny a ozařovány při nízké intenzitě 0,7 mW/cm2. Výsledky byly potvrzeny pomocí třech separátních experimentů, kdy byly pro každý časový bod použity vždy 3 paralelní vzorky. Ozáření pomocí Spectral Blue lampy po dobu 6 hodin zajistilo redukci počtu bakterií o více než 99,9 %.
Obr. 2 Inaktivace E. coli. Bakterie byly nasazeny na agarové plotny a ozařovány při nízké intenzitě 0,7 mW/cm2. Výsledky byly potvrzeny pomocí třech separátních experimentů, kdy byly pro každý časový bod použity vždy 3 paralelní vzorky. Ozáření pomocí Spectral Blue lampy po dobu 6 hodin zajistilo redukci počtu bakterií o více než 99,9 %.
Spectral Blue LED lampy jsou účinné proti:
- Všem bakteriím, kvasinkám a plísním, včetně antibioticky rezistentních kmenů rodu Staphylococcus a Enterococcus
- Virům obaleným lipidovou membránou (např. Sars-CoV-2, chřipka A)
- Mikrobiálním biofilmům
- Kompletní seznam zatím otestovaných mikroorganismů naleznete na stránkách výrobce a neustále se rozšiřuje zde: https://spectral.blue/pages/scientific-microbial-test-results-with-blue-light
Spectral Blue panely inaktivují mikroby už během 2-8 hodin oproti klasickým systémům. MWHI technologie navíc nezpůsobuje vznik antimikrobiální rezistence, na rozdíl od UV záření nepoškozuje materiály ani negeneruje nebezpečný ozon a její účinnost se dá dále zesílit ošetřením povrchů pomocí fotokatalytického oxidu titaničitého.
Kontinuální dezinfekce
Jak už bylo řečeno v předchozích odstavcích aBL je naprosto bezpečné pro lidi i materiály. Tradiční metody jako je chemická dezinfekce nebo UV záření jsou sice velmi účinné, ale pro lidi vysoce nebezpečné a jejich použití je tedy omezené na epizodické čištění, kdy se prostory sanitují např. jednou za den nebo týden nebo těsně před použitím. Epizodická dezinfekce má tudíž velmi krátkou životnost a následně dochází k rychlé opětovné kontaminaci. Spectral Blue lampy lze oproti tomu používat kontinuálně a udržovat tak nízkou hladinu mikroorganismů v prostředí po celou dobu (viz Obr. 3). Práce při modrém světle samozřejmě není úplně komfortní, a tak mají Spectral Blue systémy často zabudovaný automatický časovač nebo senzor pohybu, který světla spíná podle denní doby nebo podle toho, jestli je někdo právě v místnosti. Ideální je tak např. instalace v přechodových místnostech do výrobních prostor nebo prostor se zvýšeným biologickým rizikem.

Obr. 3 Porovnání klasické jednorázové a kontinuální dezinfekce. Při klasické jednorázové dezinfekci dochází k rychlé eliminaci mikroorganismů a zároveň rychlé rekontaminaci prostor a povrchů. Při kontinuální dezinfekci pomocí Spectral Blue světel dochází k eliminaci mikroorganismů a jejich hladina je pak kontinuálně udržována na nízké hladině.
Základní produktová řada
Základní produktovou řadu světel Spectral Blue tvoří tzv. Plug & play světla, která stačí jednoduše připojit do zásuvky a lze je nainstalovat do jakýchkoliv prostor. Vybrat si lze z několika modelů:
 |
Tento model je určený pro instalaci do laminárních boxů a je vybaven dvěma silnými magnety na zadní straně. Při instalaci tak stačí světlo přichytit na kovový strop nebo záda boxu. |
 |
Tento model určený pro dezinfekci pracovních stolů a povrchů. Jednotka se přichytí na strop, stěnu nebo polici pomocí šroubů nebo lanek.
|
 |
Berlin je model s nejvyšším výkonem pro nejrychlejší dezinfekci. Jedná se o samostojnou jednotku s výkonem 200 W a úhlem svícení 120°. Ideální do laboratoří, ordinací nebo nemocnic. |
 |
Jedná se o samostojnou jednotku s výkonem 230 W a úhlem svícení 360°. Ideální pro umístění doprostřed ordinací, laboratoří nebo jiných prostor náročných na hygienu. |
 |
Řešení na míru – pokud vám nevyhovují plug & play modely, vždy je možnost nachystat řešení na míru přímo pro Vaše prostory. Spectral Blue jsou schopni navrhnout modely pasující do vašich existujících svítidel a navrhnout ideální rozložení a intenzitu osvětlení pro vaše prostory. |
Reference
[1] Leon G. Leanse et al., Antimicrobial blue light: A ‘Magic Bullet’ for the 21st century and beyond?, Advanced Drug Delivery Reviews, Volume 180, 2022, 114057, ISSN 0169-409X, https://doi.org/10.1016/j.addr.2021.114057.
Kontaktujte nás
Pokud vás technologie dezinfekce pomocí modrého světla zaujala a chtěli byste ji vyzkoušet, neváhejte nás kontaktovat a my vám rádi poskytneme další informace a domluvíme zapůjčení Plug&Play svítidel, abyste si sami mohli ověřit účinnost.
Aplikační podpora: Ing. Vojtěch Ledvina, Ph.D., 725 320 796, vojtech.ledvina@eastport.cz
Obchodní podpora: Ing. Vojtěch Andrle, 724 241 350, vojtech.andrle@eastport.cz
Podpora všeho druhu: 235 318 177, eastport@eastport.cz
